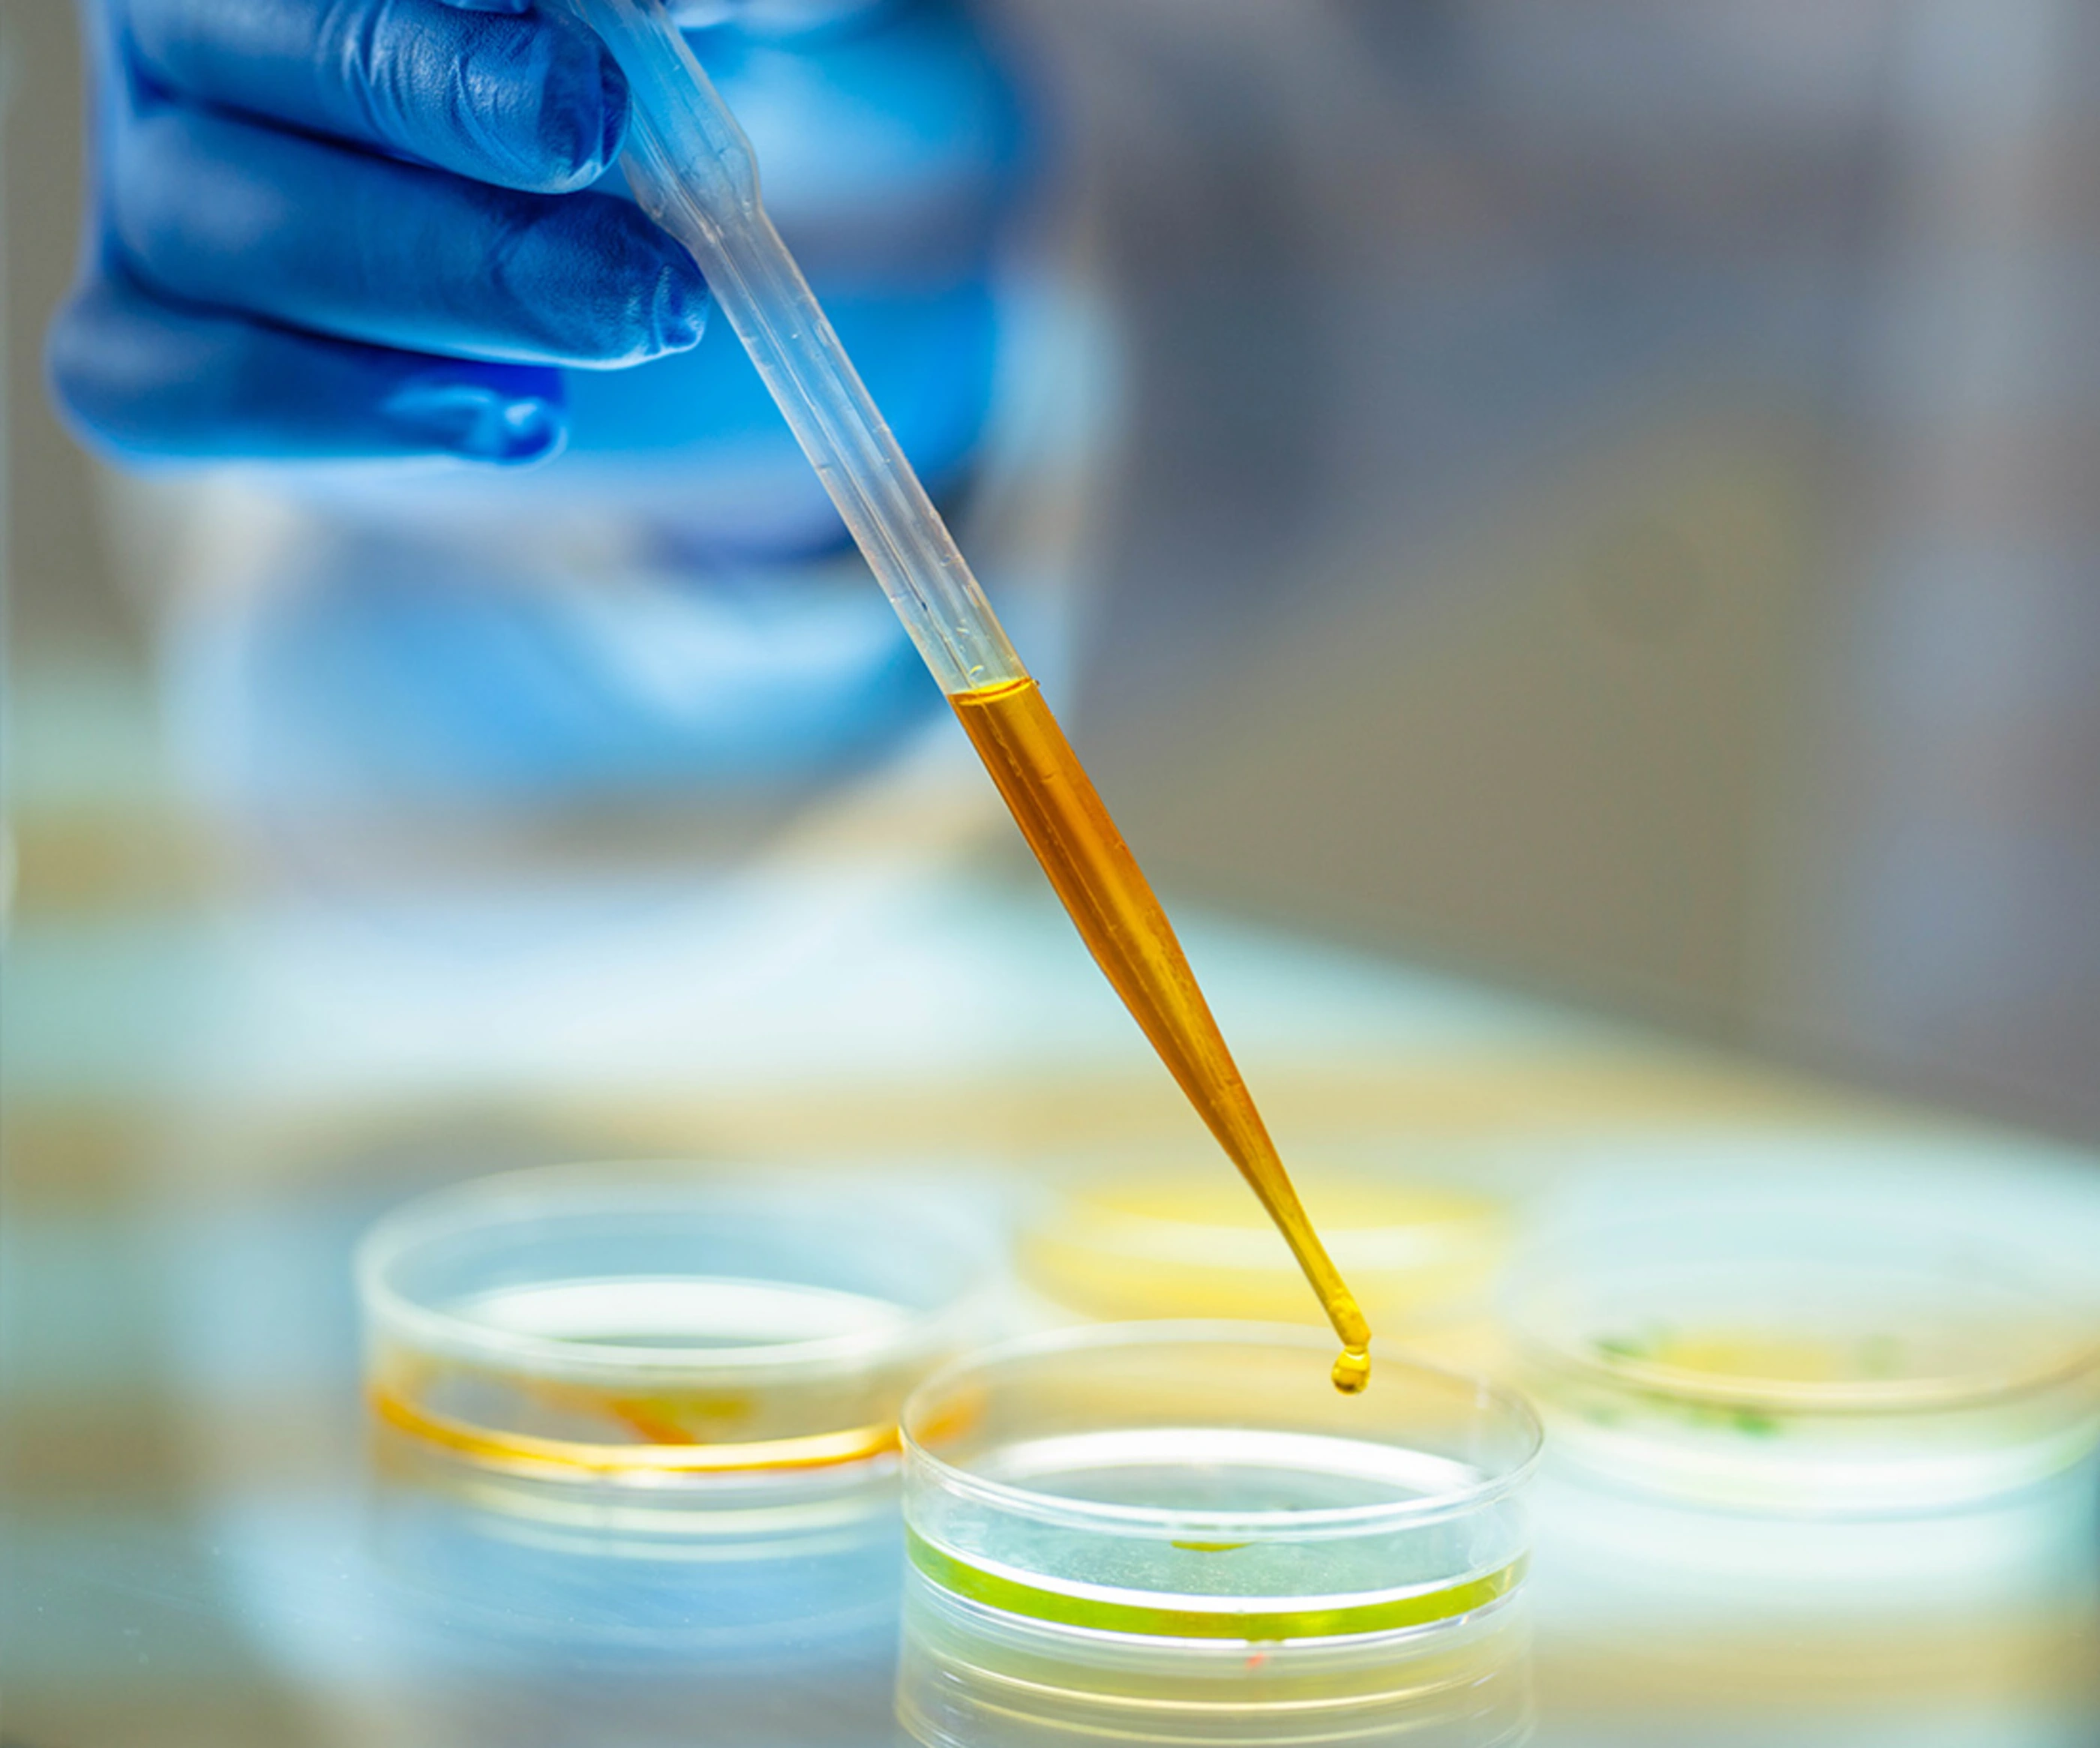
Male Medical Researcher.

Features
特長
研究開発データ(ラボデータ)を一元化するデータマネジメントプラットフォーム
実験データ・レポート・実験指示書など、ラボデータを最適な方法で共有・活用ができます。
材料開発に最適な機械学習機能、複数のモデルを搭載
材料分野の開発・研究をデジタル化する多彩な機能を搭載しています。
直感的に使用できるユーザーインターフェイス
誰でもが簡単に使用できる画面構成です。
NAGASEのデータサイエンティストによる日本語でのオンボーディングサポート
今からMIを始める組織にも最適なツールです。

Functions
機能

実験データの保存・蓄積
- 電⼦実験ノートとしてデータ蓄積が可能
- マスターを領域ごとに設定でき、過不⾜ない項⽬でのデータ取得
- 検索・フィルタリングにより、知見を可視化・有効活用
- 各種詳細な実験条件に対応
- 機器からデータを直接読み込み

データのビジュアライズ・解析・分析
- 数学的な解析に加え、多様なGUIによる視覚的な分析可能(4次元まで表示)
- 原料と物性間の相関関係をビジュアライズ表示
- 各種機械学習モデルを活用した解析

実験計画
- ベイズ最適化による実験点推奨
- 原料・物性の相関関係からの特徴量の見出しを活かした実験計画立案
- 柔軟な実験の制約条件および目標物性の設定
- MI領域の機械学習エンジニアによるアドバンストなサポートも可能

コミュニケーション
- 実験結果の構造化データをチーム間で共有
- 実験指示書やレポートなどを出力・共有化
- エクセル・紙・口頭だけに頼らないコミュニケーションを実現
Application Fields
適応分野
材料開発分野
Uncountable社のサイト(外部サイト)
※英語ドキュメント
Developers
開発元

Uncountable社は、2016年にMITとスタンフォード大学の機械学習エンジニアによって設立された、材料開発に特化したデータマネジメントプラットフォームを開発・提供しているスタートアップ企業です。 スタートアップ企業から大企業まで、あらゆる規模の企業と提携し、研究開発を加速させるソリューションを提供しています。また、Uncountableプラットフォームは、アジア、北米、欧州を中心とする材料・化学業界の大企業での採用実績があります。 日本国内においては、長瀬産業株式会社が代理店としてUncountableプラットフォームの販売・サポートを行っています。
関連商品
材料開発分野データマネジメントプラットフォーム Uncountable アンカウンタブルについてのお問い合わせ
右記のフォームにお問い合わせ内容をご入力いただき、個人情報の取り扱いに同意の上「送信する」ボタンを押してください。
その他のお問い合わせはこちら。












